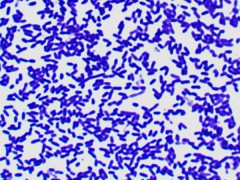

NMN是人体内固有的物质, 可通过人体自主合成,自然界中的一些水果和蔬菜也富含 NMN。据《Cell》杂志统计,如毛豆、西蓝花、黄瓜种子等含有 NMN。如毛豆中含有NMN在0.47–1.88mg/100g,属于蔬菜中NMN含量较高的品种,根据 FDA 的等效原则,一个 70Kg 的成年人每天应补充 600mg 的 NMN,一个成年人补充同等量的 NMN,则需要吃掉 32~128kg 的毛豆,或者 54~240kg 的西兰花,由此可见直接通过自然界中的食物来源补充 NMN 效率较低,而 NMN 制品可以较快达到这一效果。
全球抗衰老市场突破 1900 亿美元。伴随全球经济持续增长和人均寿命的不断攀升, 65 周岁及以上老年人口占比持续提升,全球范围对健康问题关注度持续提升,药品、保健品等市场容量持续增加。人均寿命作为人类有史以来持续努力解决的终极问题之一,在上述背景中关注度持续提升,相关市场空间不断增加。根据市场调研公司 Zion Market Research 发布的报告显示, 全球抗衰老市场规模在 2019 年达到 1917 亿美元,同比增长 8.3%。
中国保健品行业规模快速增长,当前市场规模近 4000亿元,复合增速 9.5%。近几年来随着我国消费者健康意识以及抗衰老需求的增长,我国保健品行业快速发展,2019年我国保健品行业产能 73.9万吨,同比增加 5%,产量 62.7万吨,同比增加 5%;行业 2019 年进口额达到 134亿元。根据中国影响保健协会统计,我国保健品行业市场规模从 2009 年 1600 亿元迅速增加至近 4000 亿元,行业过去 10 年复合增速 9.5%。
与欧美发达国家相比,我国保健品行业渗透率仍有较大提升空间。2019年我国保健品在不同年龄段渗透率在 10%-30%之间,而美国等发达国家 25岁及以上人口目前渗透率在 50%-75%之间,我国与发达国家渗透率差异较大,特别是 65岁及以上老年人口,中美两国保健品渗透率相差了 50个百分点。
NMN每覆盖 1%保健品人口对应 304亿元市场空间,行业远期有望达到千亿规模。当前 NMN价格在 1500元/瓶,常规包装为 60粒/瓶,目前 25-44岁人口按照每天 1粒测算,年消费金额为 9000元;45岁及以上人口按照每天 2粒测算,年消费量金额为 18000 元。
根据测算,按照当前我国各年龄段保健品市场渗透率及不同年龄段服用 NMN用量情况(即,24周岁及以下不服用,25-44周岁每日服用 1粒,45周岁及以上每日服用 2 粒),NMN每覆盖 1%国内保健品人群市场,对应的市场规模约为 304亿元。伴随抗衰老产品未来市场不断推广,如果 NMN 能覆盖当前服用保健品人口的 3%规模,其市场规模有望达到千亿。对应对NMN原料的需求为1800吨。
1500元/瓶的售价对于大多数消费者是可望不可及的,其原因在于高昂的NMN原料成本仍然是阻碍NMN市场发展的主要原因之一,据了解目前主要厂家的原料生产成本都在6000元/公斤,因此开发新的工艺,降低原料成本才能促进NMN市场发展。
本技术 以β-D-呋喃核糖为底物,与ATP在酶的催化下制得中间体,再与烟酰胺经酶催化值得NMN,纯化精制得到成品。该方法采用全酶法过程,绿色环保,原料利用率高,成本可控,大致生产成本为2500元/公斤。
目前半酶法一般NR到NMN的摩尔转化率为80%,如果要控制成本到2500,至少需要提高摩尔转化率到95%以上。